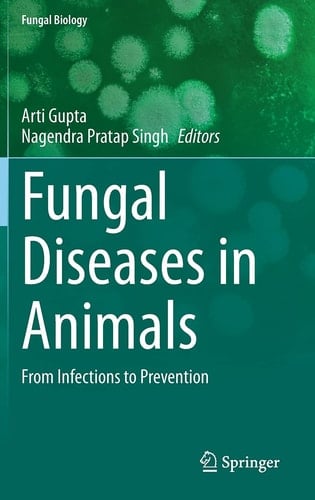
Fungal Diseases in Animals From Infections to Prevention

The importance of fungal infections in both human and animals has increased over the last few decades. This book presents an overview of the different categories of fungal infections that can be encountered in animals (including lower vertebrates) originating from environmental sources with or without transmission to humans. In addition, the endemic infections with indirect transmission from the environment, the zoophilic fungal pathogens with near-direct transmission, the zoonotic fungi that can be directly transmitted from animals to humans, mycotoxicoses and antifungal resistance in animals will also be discussed. This book includes case studies and reviews the current state of knowledge on the mechanism of fungal attraction, recognition, infection, extracellular hydrolytic enzymes and pathogenesis of nematophagous fungi. The book also covers diagnostics, fungal formulations, as well as prevention methods. It discusses strategies to access the fungal pathogen groups, metagenomic analyses, genomics, secretomics, metabolomics, proteomics and transcriptomics. In addition, pathogen description, understanding, distribution and recent research results are provided.
Page Count:
191
Publication Date:
2021-06-23
ISBN-10:
3030695069
ISBN-13:
9783030695064
No comments yet. Be the first to share your thoughts!